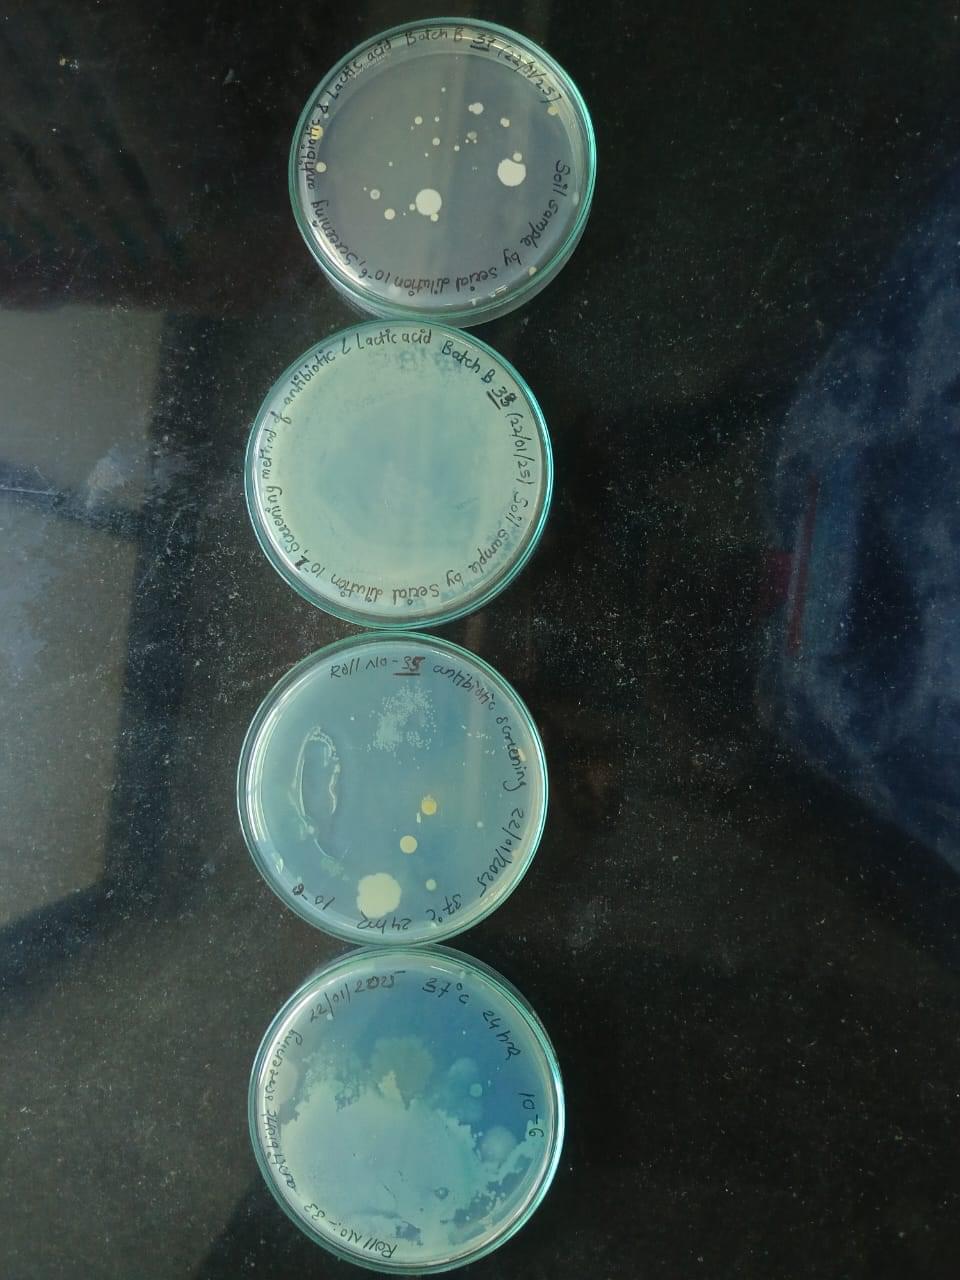

The scholarship program at Mumbai University and the State Government offers financial aid primarily to non-open category students, with opportunities for open category students to earn scholarships through academic merit. Fees at the college vary based on category and course, with examples including 34,000 INR annually for open category students and reduced fees of 28,000 INR for students with caste certificates. Notable scholarships include the RUSA and Chhatrapati Rajshri Shahu Maharaj, which offer significant fee reductions.
The tuition and associated fees for courses like B.Sc vary from as low as 8,000 INR to 50,000 INR per year, depending on the course and category. The college provides installment payment options, loans, and aids for students who cannot fully cover the fees. Additionally, scholarships and financial aid are accessible for OBC, SC, ST, and other reserved categories, offering substantial fee waivers. The college also facilitates job placements and internships, though opportunities might be limited for certain degrees like BA.

![Changu Kana Thakur Arts, Commerce and Science College - [CKT]](https://image-static.collegedunia.com/public/college_data/images/logos/1748314974CKTNameBannertop.jpg?h=71.7&w=71.7&mode=stretch)

.jpeg?h=78&w=78&mode=stretch)


![Veer Wajekar Arts Science and Commerce College - [VWASCC]](https://image-static.collegedunia.com/public/college_data/images/appImage/5295_VWA_New.jpg?h=111.44&w=263&mode=stretch)









![Kishinchand Chellaram College - [KC College]](https://image-static.collegedunia.com/public/college_data/images/appImage/2216_Untitled.jpg?h=111.44&w=263&mode=stretch)








.jpeg?h=72&w=72&mode=stretch)



![Pillai HOC College of Engineering and Technology - [PHCET]](https://image-static.collegedunia.com/public/college_data/images/logos/1709543727PHCETLogo21.png?h=72&w=72&mode=stretch)
![MGM Institute of Management Studies & Research - [MGMIMSR]](https://image-static.collegedunia.com/public/college_data/images/logos/1476696020111.jpg?h=72&w=72&mode=stretch)
![Sanpada College of Commerce and Technology - [SCCT]](https://image-static.collegedunia.com/public/college_data/images/logos/1479302726scct.jpg?h=72&w=72&mode=stretch)
![Shikshan Maharshi Dadasaheb Limaye College - [SMDL]](https://image-static.collegedunia.com/public/college_data/images/logos/1428744135jp.jpg?h=72&w=72&mode=stretch)
![Pillai College of Arts, Commerce and Science - [PCACS]](https://image-static.collegedunia.com/public/college_data/images/logos/1649334951Screenshot20220407180534.png?h=72&w=72&mode=stretch)



.jpg?h=72&w=72&mode=stretch)
![Veer Wajekar Arts Science and Commerce College - [VWASCC]](https://image-static.collegedunia.com/public/college_data/images/logos/1427867835jpeg.jpg?h=72&w=72&mode=stretch)
![Mahatma Phule Arts, Science and Commerce College -[MPASCC]](https://image-static.collegedunia.com/public/college_data/images/logos/1472733513jkfhds.jpg?h=72&w=72&mode=stretch)
![Karamveer Bhauro Patil College - [KBP College]](https://image-static.collegedunia.com/public/college_data/images/logos/1685101111Screenshotfrom20230526170814.png?h=72&w=72&mode=stretch)
![Pillai HOC College of Arts, Science and Commerce - [PHCASC]](https://image-static.collegedunia.com/public/college_data/images/logos/1649707807PHCASCnewheader.png?h=72&w=72&mode=stretch)
![St.Wilfred’s College of Arts, Commerce & Science- [SWCACS]](https://image-static.collegedunia.com/public/college_data/images/logos/1656990925images.png?h=72&w=72&mode=stretch)



Comments